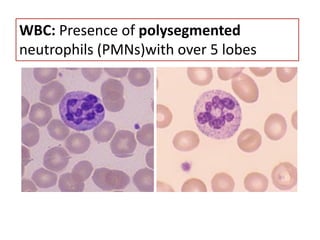
WBC: Presence of polysegmented
neutrophils (PMNs)with over 5 lobes
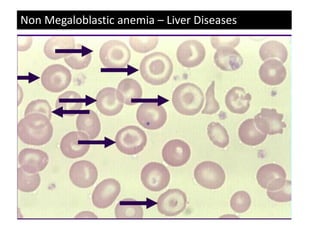
Non Megaloblastic anemia – Liver Diseases

This document discusses megaloblastic anemia, its causes, symptoms, and diagnostic tests. It begins by defining megaloblastic anemia as a group of disorders caused by deficiencies in vitamin B12 or folic acid. These deficiencies result in impaired DNA synthesis and defective cell maturation. Key symptoms include anemia, diarrhea/constipation, and glossitis. Diagnostic tests involve measuring serum levels of B12, folate, and homocysteine. Pernicious anemia, a type of megaloblastic anemia, is also discussed and is characterized by autoimmune destruction of gastric parietal cells and the absence of intrinsic factor.